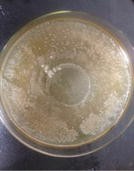

Table 1 Colony morphology comparison of TMP and TSP
TMP | TSP | |
|---|---|---|
Image |
|
|
Size | Medium-sized, 1–5 mm diameter | Small, compact arrangement |
Form | Round, regular edges | Round, regular edges |
Protruding | Slightly bulging | Raised |
Surface state | Smooth | Smooth |
Surface gloss | Glossy | Little glossy |
Texture | Wet and sticky, easy to pick | Sticky, difficult to pick |
Color and transparency | Thick and white | White and transparent |